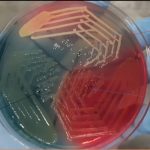
Cystine Lactose Electrolyte Deficient (CLED) Agar: Introduction, Uses,Composition, Preparation, Colony Characteristics, Modification and Limitations

Tag: Typical Colony Morphology on CLED Agar is as follows:
CLED Medium: Introduction, Uses,Composition, Preparation, Colony Characteristics, Modification and Limitations
 Introduction of CLED Medium CLED stands for cysteine, lactose, and...
Introduction of CLED Medium CLED stands for cysteine, lactose, and...
Cystine Lactose Electrolyte Deficient (CLED) Agar: Introduction, Uses,Composition, Preparation, Colony Characteristics, Modification and Limitations
Introduction of Cystine Lactose Electrolyte Deficient (CLED) Agar CLED stands...
Introduction of Cystine Lactose Electrolyte Deficient (CLED) Agar CLED stands...
